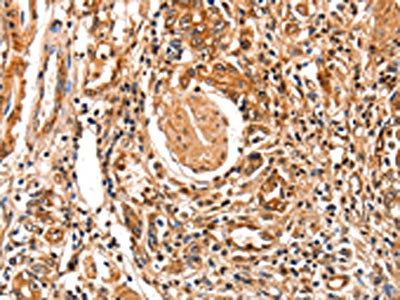

FABP7 Antibody
-
中文名稱:FABP7兔多克隆抗體
-
貨號:CSB-PA066650
-
規格:¥1100
-
圖片:
-
The image on the left is immunohistochemistry of paraffin-embedded Human breast cancer tissue using CSB-PA066650(FABP7 Antibody) at dilution 1/25, on the right is treated with fusion protein. (Original magnification: ×200)
-
The image on the left is immunohistochemistry of paraffin-embedded Human stomach cancer tissue using CSB-PA066650(FABP7 Antibody) at dilution 1/25, on the right is treated with fusion protein. (Original magnification: ×200)
-
Gel: 8+12%SDS-PAGE, Lysate: 30 μg, Lane: Human fetal brain tissue, Primary antibody: CSB-PA066650(FABP7 Antibody) at dilution 1/350, Secondary antibody: Goat anti rabbit IgG at 1/8000 dilution, Exposure time: 30 seconds
-
-
其他:
產品詳情
-
Uniprot No.:
-
基因名:
-
別名:B FABP antibody; B-FABP antibody; BFABP antibody; BLBP antibody; Brain lipid binding protein antibody; Brain lipid-binding protein antibody; Brain-type fatty acid-binding protein antibody; DKFZp547J2313 antibody; FABP 7 antibody; FABP7 antibody; FABP7_HUMAN antibody; FABPB antibody; Fatty Acid Binding Protein 7 antibody; Fatty acid binding protein 7 brain antibody; Fatty acid binding protein brain antibody; Fatty acid-binding protein 7 antibody; Fatty acid-binding protein, brain antibody; Mammary derived growth inhibitor related antibody; Mammary-derived growth inhibitor related antibody; MRG antibody; OTTHUMP00000017119 antibody
-
宿主:Rabbit
-
反應種屬:Human,Mouse,Rat
-
免疫原:Fusion protein of Human FABP7
-
免疫原種屬:Homo sapiens (Human)
-
標記方式:Non-conjugated
-
抗體亞型:IgG
-
純化方式:Antigen affinity purification
-
濃度:It differs from different batches. Please contact us to confirm it.
-
保存緩沖液:-20°C, pH7.4 PBS, 0.05% NaN3, 40% Glycerol
-
產品提供形式:Liquid
-
應用范圍:ELISA,WB,IHC
-
推薦稀釋比:
Application Recommended Dilution ELISA 1:1000-1:5000 WB 1:500-1:2000 IHC 1:25-1:100 -
Protocols:
-
儲存條件:Upon receipt, store at -20°C or -80°C. Avoid repeated freeze.
-
貨期:Basically, we can dispatch the products out in 1-3 working days after receiving your orders. Delivery time maybe differs from different purchasing way or location, please kindly consult your local distributors for specific delivery time.
-
用途:For Research Use Only. Not for use in diagnostic or therapeutic procedures.
相關產品
靶點詳情
-
功能:B-FABP could be involved in the transport of a so far unknown hydrophobic ligand with potential morphogenic activity during CNS development. It is required for the establishment of the radial glial fiber system in developing brain, a system that is necessary for the migration of immature neurons to establish cortical layers.
-
基因功能參考文獻:
- Normal sleep requires the astrocyte brain-type fatty acid binding protein FABP7. PMID: 28435883
- BLBP was highly expressed in glioblastoma tissues.Increased BLBP expression in glioblastoma is associated with poor survival.BLBP mediates the proliferation of human glioblastoma cells by regulating ERK1/2 signaling pathway. PMID: 29288341
- Data indicate that the levels of fatty acid binding protein 7 (FABP7) dramatically decreased during passage of the renal cell carcinomas (RCCs) cell line TUHR14TKB. PMID: 28292269
- FABP7 is overexpressed in clear cell renal cell carcinoma and promotes cell growth by the activation of ERK and Stat3 signaling pathways PMID: 25192834
- FABP7 and HMGCS2 may have roles in apocrine differentiation categorizing apocrine carcinoma of the breast PMID: 25389781
- The mRNA/protein expressions of FABP7 was lower in the stenotic colon segment tissue than in the normal colon segment tissue of Hirschsrung disease patients. PMID: 24966941
- These results suggest an important role of Rev-erbalpha and Fabp7 in adult neurogenesis. PMID: 24932636
- identified 98 transposable element-FABP7 gene chimeric transcripts that were exclusively expressed in primary diffuse large B-cell lymphoma (DLBCL) cases and confirmed several in DLBCL-derived cell lines PMID: 25114248
- FABP7 and FABP5 are differentially expressed in oligodendrocyte lineage cells and regulate their proliferation and/or differentiation. PMID: 24114376
- Our data introduces FABP7 as a marker for glioma stem cells and further highlights its possible significance for glioma diagnosis and treatment. PMID: 24274717
- Report feasibility of detecting B-FABP as biomarker for ischemic brain damage during extrcorporeal circulation in coronary artery bypass grafting patients. PMID: 23020859
- FABP7 is almost exclusively expressed in neurospheres and not in the adherent cells, derived from the same glioblastoma tumor. PMID: 23284888
- A fatty acid-binding protein 7/RXRbeta pathway enhances survival and proliferation in triple-negative breast cancer. PMID: 22322885
- Considerable heterogeneity in expression patterns of FABP7 within breast cancer elates to differences in biological behaviour especially in basal-like breast cancer. PMID: 22562177
- identified its binding target by proteomic analysis as fatty acid binding protein 7 (FABP7), also known as brain lipid binding protein) which is highly expressed in neural stem cells and localized in the cytoplasm PMID: 22689954
- These data provide the first evidence of direct transactivation of the FABP7 proximal promoter by PAX6 and suggest a synergistic mechanism for PAX6 and other co-factor(s) in regulating FABP7 expression in malignant glioma. PMID: 22583899
- Data show that three putative FABP7 promoter regions drive reporter gene expression in renal cell carcinoma cell lines, but not in the HEK293 cell line. PMID: 21771320
- expression of BLBP in activated astrocytes negatively correlates with disease duration and in parallel with remyelination failure PMID: 21620951
- BFABP is involved in cell proliferation and migration of human renal carcinoma cells. PMID: 21399875
- High FABP7 is associated with malignant glioma. PMID: 20834042
- We have identified a novel subgroup of basal phenotype (BP) class of breast cancers showing FABP7 expression that have significantly better clinical outcome. PMID: 19590950
- this study is the first to demonstrate overexpression of FABP-7 in triple-negative breast cancers PMID: 19608352
- FABP7 may function as a tumor progression gene in melanoma PMID: 19587692
- overall structure exhibits the typical backbone conformation described for other members of the FABP family, consisting of antiparallel beta-strands that form two almost orthogonal beta-sheets, a helix-turn-helix motif and a short N-terminal helical loop PMID: 12479569
- BLBP, stimulated by Ras-independent pathways, regulates Schwann cell-axon interactions in normal peripheral nerve and peripheral nerve tumors. PMID: 12612091
- Overexpression of FABP7 in Down syndrome fetal brains. PMID: 12771203
- data indicate that MRG is a mediator of the differentiating effects of pregnancy on breast epithelium PMID: 12975368
- A possible mechanism for the association of nuclear FABP7 & poor prognosis of glioblastoma multiforme is that nuclear FABP7 may be induced by EGFR activation to promote migration of GBM tumor cells. PMID: 16623952
- relation between FABP7, astrocytic features, invasion and poor prognosis and suggests that EGFR amplification is associated with nuclear translocation of FABP7. PMID: 17415524
- There were not significant difference in B-FABP expression between ductal infiltrating carcinoma and benign tissue in human breast cancer. PMID: 17428383
- Upregulation of FABP7 in renal cell carcinoma was confirmed by quantitative RT-PCR. PMID: 17646957
- B-FABP expression in malignant glioma cells is accompanied by the appearance of radial glial-like properties, as well as reduced transformation. B-FABP depletion results in decreased migration, reduction in cell processes, & a more transformed phenotype. PMID: 17898869
- Decreased expression of FABP-7 in fetal cystic adenomatoid malformation (CCAM) suggests FABP-7 may have a role in pulmonary development and in the pathogenesis of CCAM. PMID: 18391847
- Both in vitro Reelin treatment and overexpression of Notch-1 intracellular domain induced BLBP expression and a radial glial phenotype in an immortalized human neural progenitor cell line, isolated from the cortex of 14 weeks old fetus PMID: 18593473
- High expression of FABP7 is associated with melanoma PMID: 18826602
- NFI family of transcription factors plays a key role in the regulation of both the B-FABP and GFAP genes in malignant glioma cells. PMID: 19540848
- Increases tumor cell motility in vitro and over-expression is associated with poor prognosis in glioblastoma patients PMID: 15827123
- Functional analysis in mice. PMID: 12975368
顯示更多
收起更多
-
亞細胞定位:Cytoplasm.
-
蛋白家族:Calycin superfamily, Fatty-acid binding protein (FABP) family
-
組織特異性:Expressed in brain and other neural tissues.
-
數據庫鏈接:
Most popular with customers
-
-
Phospho-YAP1 (S127) Recombinant Monoclonal Antibody
Applications: ELISA, WB, IHC
Species Reactivity: Human
-
-
-
-
-
-